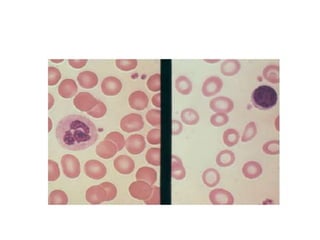
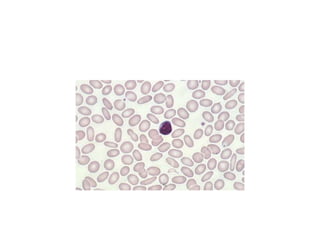

The document provides information about examining a blood smear under Wright's stain and identifying different blood cell morphologies:
- The feathered edge of a blood smear is the best place to examine red blood cell morphology, where they lie in a single layer without overlapping.
- Red blood cells can be identified as microcytic, macrocytic, or anisocytic based on their size compared to a lymphocyte nucleus, and as poikilocytic if their shape varies greatly.
- Abnormal red blood cell shapes include spherocytes, schistocytes, acanthocytes, and different inclusions like Howell-Jolly bodies, nuclei, parasites, and Heinz bodies can indicate